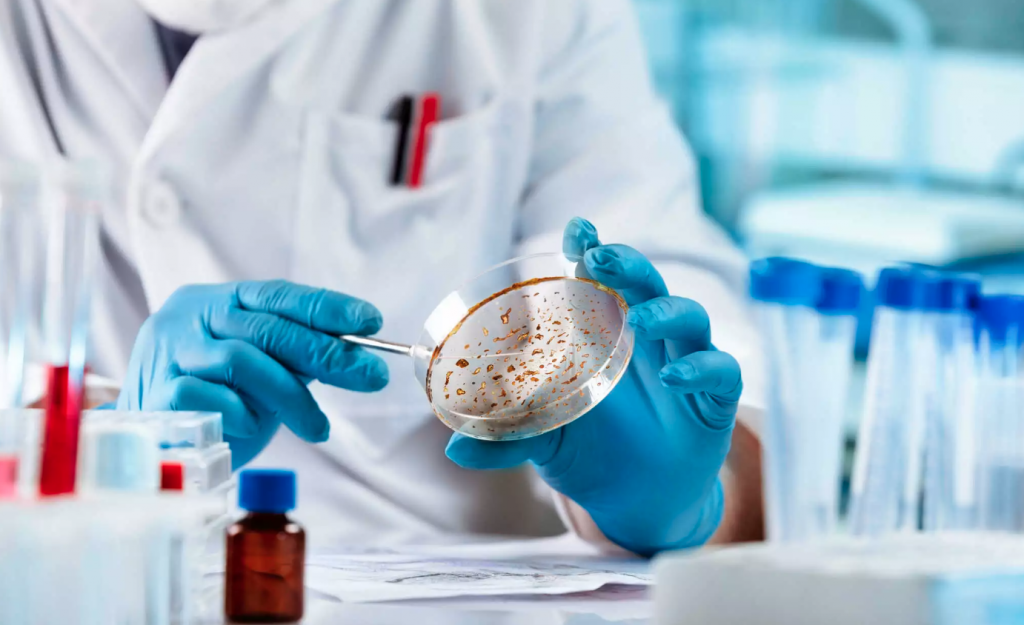

Όπως όλα δείχνουν, το Market pass φαίνεται πως θα πάρει παράταση μετά τις εκλογές της 25η Ιουνίου.
Οι αυξήσεις σε προϊόντα πρώτης ανάγκης στα ράφια των σούπερ μάρκετ κάνει την παράταση του μέτρου επιτακτική με τους πολίτες να αδυνατούν να ανταπεξέλθουν στα καθημερινά τους έξοδα.
Υπενθυμίζεται ότι το μέτρο ισχύει μέχρι τον Ιούλιο.
Σχέδιο επέκτασης Market pass για 3.000.000 δικαιούχους
Εξετάζεται:
– Επέκταση Market Pass: Έως 31/12/2023
– Διάρκεια επιδότησης: 5μηνη (Αύγουστο – Δεκέμβριο 2023)
– Δυνατότητα: Υποβολής νέων αιτήσεων
* Αφορά: Όσους έχουν απορριφθεί
– Υφιστάμενοι δικαιούχοι: Επέκταση επιδόματος χωρίς αίτηση
– Ενίσχυση: Σύνολο νοικοκυριού (όχι μεμονωμένα)
– Φιλοξενούμενοι: Δεν επιδοτούνται
– Μηνιαία επιδότηση: 22 € έως 100 € (Έως 500 € 5μηνο)
– Κατάθεση σε ψηφιακή κάρτα: 100% επιδότησης
– Αγορές: Σούπερ μάρκετ, παντοπωλεία, κρεοπωλεία, ζαχαροπλαστεία, γαλακτοπωλεία, φούρνοι, ιχθυοπωλεία, λαϊκές
– Κατάθεση σε λογαριασμό: 80% επιδότησης
– Χρήματα στο λογαριασμό:
* Δεν απαιτούνται αγορές
* Χρήση για οποιοδήποτε σκοπό
Εισοδηματικά και περιουσιακά κριτήρια
Ετήσιο εισόδημα 2022 (νέες αιτήσεις)
* Άγαμοι: Έως 16.000 €
* Έγγαμοι – μονογονεικές: Έως 24.000 €
* Για κάθε παιδί ή επιπλέον μέλος: Συν 5.000 €
Αντικ. Αξία ακινήτων (ΕΝΦΙΑ 2023):
* Άγαμοι: Έως 250.000 €
* Έγγαμοι – Μονογονεϊκές: Έως 400.000 €